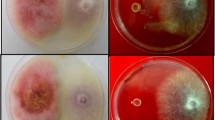

Abstract
The in vitro ability to produce enzymes and the toxicological influence of culture filtrates from potential fungal plant pathogens on seed germination, sprout growth, stabilization of cell membranes (electrical conductivity of exudates), and growth of seedlings of garden cress (Lepidium sativum L.) were investigated. The fungi used in the study showed significantly different ability to secrete enzymes with different activities. The highest amylolytic activity was shown by Fusarium oxysporum (Fo2), proteolytic activity by F. sulphureum (Fs1564), Gibberella avenacea (Ga2) and G. intricans (Gi2), cellulitic activity by Haematonectria haematococca (Hh776), and pectinolytic activity by strains Fo1 and Fo2 of F. oxysporum. All the fungal filtrates significantly reduced percentages of seed germination, the growth of sprout and seedlings, and destabilization of cell membranes in seedlings. Fusarium poae (Fp2) and G. fujikuroi (Gf1) most strongly reduced seed germination and sprout growth, whereas G. fujikuroi (Gf1) most strongly affected growth and destabilization of cell membranes in seedlings. Fungal enzyme abilities, and in particular pectinase synthesis, do not determine the impact of their culture filtrates on seeds and seedlings. Probably other secondary metabolites synthesized by F. poae (Fp2) and G. fujikuroi (Gf1) have a negative influence on seeds and seedlings of garden cress. The plant used in this study is very sensitive to external factors. Therefore, in the near future, different model plants e.g., cereals, which are less sensitive to external factors, will be used for in-depth characterization of the toxicological influence of culture filtrates from Fusarium spp. and Gibberella spp. on plants.
Similar content being viewed by others
Avoid common mistakes on your manuscript.
Introduction
Garden cress (Lepidium sativum L.) is edible with medicinal properties and a fast growing annual herb belonging to the Brassicaceae family. This herb is cultivated all over India, North America and parts of Europe, and it is often used in in vitro and in vivo studies, because it is easy to breed, grows rapidly, small in size and is sensitive to external factors (Tuncay et al. 2011; Agarwal and Sharma 2013; Wagh et al. 2013; Sharma et al. 2015). Therefore, cress can be a good alternative in toxicity tests for duckweed (Lemna minor and L. gibba), which is very often used in such tests (Fairchild et al. 1997, 2009; Marwood et al. 2001). Moreover, garden cress is popular in terms of consumers and producers because of its peppery taste and having health promoting substances such as glucosinolates and sterols (Raval and Pandya 2011; Tuncay et al. 2011; Wagh et al. 2013).
Garden cress (seeds and plants) on account of its chemical composition and health benefits is used for animals as fodder and in treating and curing certain diseases of humans (Maier et al. 1998; Gokavi et al. 2004; Su and Arab 2006; Juma 2007; Diwakar et al. 2010; Doke and Guha 2014). The herb is used for treating and preventing vitamin C deficiency, constipation, and poor immunity and as a diuretic. The seeds are useful in dysenteric diarrhea, in febrile and catarrhal infections, and they have hypoglycemic activity as well as antihypertensive activity. They are also considered to be an aphrodisiac, lactagogue, galactogogue and emmenagogue (Eddouks et al. 2005; Datta et al. 2011; Rehman et al. 2012; Agarwal and Sharma 2013).
Crop losses due to fungal pathogens represent one of the most serious threats to global food production; e.g., cereal plants are subject to attack from a diverse array of fungal pathogens including biotrophs such as rust fungi that feed on living cells and necrotrophs such as Fusarium pathogens that kill host cells to obtain nutrients (Gardiner et al. 2012). Fusarium is a cosmopolitan genus of filamentous ascomycete fungi that includes many plant pathogens and mycotoxigenic fungi, posing a threat to plant and animal health and food safety (O’Donnell et al. 2013; Ma et al. 2013).
Fusarium spp. cause diseases of plants in agricultural and natural ecosystems such as Fusarium head blight or scab of cereals, sudden death syndrome of soybeans, ear rot of maize, blights, vascular wilts, rots, and cankers (O’Donnell et al. 1998, 2000; Desjardins et al. 2002; Aoki et al. 2005; van der Does et al. 2008; Coleman et al. 2009). These fungi produce a diverse array of toxic secondary metabolites, the most important Fusarium mycotoxins being fumonisins, zearalenone and trichothecenes: deoxynivalenol, nivalenol and T-2 toxin (Desjardins et al. 1996; Bai et al. 2002; Desmond et al. 2008; Ilgen et al. 2008; Ma et al. 2013; Woloshuk and Shim 2013).
Fungal culture filtrates may contain their metabolites, which are substances discharged by fungi in their metabolic processes. The metabolites are products of some amino acids, mycotoxins, cyclic peptides, aromatic, phenols, terpenoids and plant growth regulators (Nema 1992; Madhosing 1995; Desjardins et al. 1996; Bai et al. 2002; Desmond et al. 2008; Ilgen et al. 2008; Ma et al. 2013; Woloshuk and Shim 2013). For example, fungal toxins are known to cause destruction of plants by causing necrosis, chlorosis, wilting and sometimes by inhibiting seed germination (Idris et al. 2003). In addition, experiments with pathogen culture filtrates have shown that tissue response in vitro may correlate with disease reaction of the host variety, and, where this occurs, the use of culture filtrates may allow selection of important traits in disease resistance in vitro (Daud 1986; Svábová et al. 2011). Fungi of the genus Fusarium are also known to produce biologically active secondary metabolites in their cultures filtrates, often displaying phytotoxicity in tests on tissue culture plantlets, calli and cellular suspensions of many plant species (McLean 1996).
Plant diseases caused by Fusarium spp. and their secondary metabolites induced losses to crop yield and quality are responsible for multi-billion US dollar losses to world agriculture annually (Wu 2007). In addition, these fungi are responsible for keratitis and finger and toenail infections in immunocompetent humans, as well as life-threatening infections in humans with chronically low levels of white blood cells (Chang et al. 2006; Sutton and Brandt 2011). Currently, at least seven alternative generic names based on sexual stages are linked to Fusarium e.g., Gibberella, Nectria, and Neocosmospora (Geiser et al. 2013).
The aim of this study was to determine the enzymatic activity of potential fungal plant pathogens and the effect of their culture filtrates on the seed germination and the seedling growth rate of garden cress (Lepidium sativum L.).
Material and methods
Identification and isolation of fungi from host plants
One hundred seeds (from each host plant: Maize – Zea mays L., Spring barley – Hordeum vulgare L., Winter wheat – Triticum aestivum L.) were surface disinfected in sodium hypochlorite (1 % available chlorine) for 10 min and plated on sterile PDA medium (Potato Dextrose Agar, Biocorp) in 90 mm Petri dishes. The incubation of the seeds on Petri dishes was carried out at room temperature (22 °C) for 4–10 days in the darkness. After incubation, emerging colonies of fungi on the plates were subcultured on PDA media (isolates were purified by the single spore method) for identification of species using macro- and microscopic observations, namely the morphology of hyphae, conidia and sporangia, of the colonies that had grown on PDA medium and using diagnostic keys (Boot 1971; Nelson et al. 1983). Further studies were executed on selected isolates of Fusarium and Gibberella spp. among all other fungi isolated from the seed, and two species (Fusarium sulphureum Schltdl. – 1564, Haematonectria haematococca (Berk. & Broome) Samuels & Rossman – 776) obtained from the Bank of Plant Pathogens (Table 1).
Fungal culture filtrate preparation
Five discs (0.3 cm diameter) of mycelia and spores taken from the periphery of 10-day-old culture of each fungus grown on PDA medium were introduced into 250-mL conical flasks, each containing 50 mL of Czapek Dox broth (Biocorp) in the case of enzyme assay or Sabouraud dextrose broth (peptone 10 g L−1 and glucose 40 g L−1) in the case of assessment of the effects of culture filtrates on the seed germination and the seedling growth rate of garden cress. The flasks were incubated at 25 ± 1 °C for 14 days. The fungal filtrates were obtained by passing the culture through a sterile Whatman No. 3 filter paper to obtain a cell-free filtrate. After that the filtrate was passed again through a bacterial filter (0.45 μm).
Enzyme assay
Fungal strains were screened for the production of amylases, proteases, cellulases and pectinases by plate assay.
Media used to measure fungal enzymatic activity
The media included: phosphate buffer, agar and a substrate suitable for a given enzymatic reaction (Table 2). Such appropriately prepared substrates were then boiled and 25 mL was poured into Petri dishes with a diameter of 90 mm. After solidification of the substrates, five holes were cut in each dish, with a diameter of 7 mm. Then, to each hole, 0.1 mL of the filtrate was applied. Each variant of the experiment was carried out on three dishes (15 holes). The content of the enzymes in the medium was determined by measuring the width of the colored area formed as a result of the enzymatic reaction, and then converted to enzymatic units (EU) in 1 mL of the medium, using standard curves.
Standard curves
The enzymes, with established titer, were added to the holes cut in the substrates, with a diameter of 7 mm. Based on the obtained results, calibration curves were constructed and the number of enzymatic units contained in the fungal filtrates was identified. To check the pectolytic activity, pectinase from Aspergillus niger (Pectinase, Fluka) was used, dissolved in 0.1 M phosphate buffer, pH 6.3 (22 mL 0.1 M Na2HPO4 and 78 mL 0.1 M KH2PO4), to give 12.65 EU in 1 mL. The proteolytic and amylolytic activity was verified by adding to the holes either 0.1 mL 3.6 EU of amylase and 1 mL 0.2 EU of protease (Panzytrat 10000, Knoll AG), dissolved in phosphate buffer, pH 6 (12.1 mL 0.1 M Na2HPO4 and 78 mL 0.1 M KH2PO4). The cellulolytic activity was verified by adding to the hole 0.1 mL 0.0255 EU of cellulase from Trichoderma longibrachiatum (Fluka), dissolved in phosphate buffer, pH 6 (12.1 mL 0.1 M Na2HPO4 and 78 mL 0.1 M KH2PO4).
Effect of fungal culture filtrate on seeds and seedlings of garden cress
Seeds of cress were purchased from PNOS Ozarow Mazowiecki S.A. (Poland). Undamaged seeds were separated from damaged seeds and surface disinfected using 0.5 % sodium hypochlorite solution for 1 min and rinsed 4 times in sterile distilled water.
Effect of fungal culture filtrate on seed germination
Thirty surface disinfected seeds in six replicates were placed in sterilized Petri dishes (90 mm) lined with a double layer of filter paper, moistened with 3 mL of each fungal filtrate and incubated at room temperature (25 ± 2 °C) for 48 h with a daily light period. Thereafter, another 3 mL of fungal filtrate was added. The control samples were seeds presoaked in sterile distilled water or medium instead of fungal filtrates for the same periods of time. After 3 and 6 days of incubation (the time from placing of seeds in Petri dishes), Petri dishes were observed, the percentage of germinated seeds was counted and the length of sprouts was measured.
Effect of fungal culture filtrate on seedling growth
Thirty surface disinfected seeds in six replicates were placed in sterilized Petri dishes (90 mm) lined with a double layer of filter paper, moistened with 9 mL of sterile distilled water and incubated at room temperature (25 ± 2 °C) for 72 and 120 h with a daily light period. After each incubation period, 3 mL of fungal filtrates was added to each Petri dish. The control samples were seeds were presoaked in sterile distilled water or medium instead of fungal filtrates for the same periods of time. After 7 days of incubation (the time from placing of seeds in Petri dishes), seedlings of each replicate were washed in 250-mL conical flasks containing 150 mL of redistilled water and used for further studies (measurement of the length of the plants and electrical conductivity).
Measurement of length of seedlings and top leaves
Measurements were made using 30 seedlings and 30 top leaves (each from a different plant) in three replications. The seedlings were measured from the base of the stem to the bottom of the leaves, and with feather-like leaves – the top leaf (Fig. 1). Then, the same plants were used to measure electrical conductivity of exudates.
Measurement of electrical conductivity of exudates
In 250 mL conical flasks containing 50 mL of redistilled water, either 30 seedlings, or 30 feather-like leaves (each from a different plant) were placed in three replications. They were then incubated (ca. 22 °C) for 20 h, shaken for 30 min, and, as a result, exudates were obtained, using a plastic sieve. Forty mL of the exudate was poured into a glass dish and its electrical conductivity was measured using a conductivity meter, type OK 102/1 (Radelkis) at 23 °C.
Statistical analysis
The results were analyzed by ANOVA, using the Statistica 12.0 package. Means were compared using the Tukey HSD (honest significant difference) test at α ≤ 0.01. Percentage data, before analysis of variance, were transformed to Bliss (1934) angular degrees by the formula y=arcsin (value%)−0.5. After transformation, the variance was approximately constant, allowing analysis of variance to compare particular components.
Results
The fungi used in the study showed a difference in the ability to secrete enzymes with different activities – 95.2 % of strains synthesized protease, 81 % cellulase, 66.7 % amylase and only 38.1 % pectinase. Average enzymatic activity from all fungi ranged from 1.49 × 10−5 EU per 1 mL of medium for cellulases to 0.2 × 10−1 for pectinases. The highest amylolytic activity was shown by Fusarium oxysporum (Fo2), proteolytic activity by F. sulphureum (Fs1564), Gibberella avenacea (Ga2) and G. intricans (Gi2), cellulitic activity by Haematonectria haematococca (Hh776), and pectinolytic activity by both strains of F. oxysporum (Fo1 and Fo2) (Table 3).
Generally, culture filtrates from potential plant pathogenic fungi significantly limited the percentage of garden cress seeds germinated compared to the controls (medium, distilled water) in both incubation periods. The control with distilled water did not show limited seed germination. The same was true for sprout length of this plant. In the case of seed germination there were no significant differences between incubation periods, but in the case of sprout growth there were significant differences for both controls – after 6 days of incubation, increased sprout growth rate (Figs. 2 and 3).
Effect of fungal culture filtrates on seed germination of garden cress (Lepidium sativum L.). *Means followed by the same letter are not statistically different at the α ≤ 0.01 level according to the Tukey HSD test; others are. Small letters indicate the differences in the % of germinated seeds in a given incubation period. Capital letters indicate the difference in the % of germinated seeds within the length of sprout after different incubation period
Effect of fungal culture filtrates on length of garden cress (Lepidium sativum L.) sprouts. *Means followed by the same letter are not statistically different at the α ≤ 0.01 level according to the Tukey HSD test; others are. Small letters indicate the differences in the length of sprout in a given incubation period. Capital letters indicate the difference within the length of sprout after different incubation period
Culture filtrates obtained from individual strains differently affected cress seeds and their values were statistically significant. On the other hand, the differences between incubation periods in only a few cases were statistically different. In the case of seed germination significant differences were observed between study periods for fungal filtrates from strains such as F. reticulatum (Fr1), F. reticulatum (Fr2), F. sulphureum (Fs1564) and G. pulicaris (Gp1), whereas in the case of sprout growth rate it was the case for filtrates from F. oxysporum (Fo2), F. poae (Fp2) and G. fujikuroi (Gf1). After 3 days of incubation, the weakest influence on germination of the cress seeds was caused by filtrates of F. culmorum (Fc1), G. pulicaris (Gp2) and G. zeae (Gz1, Gz2) – comparably as the control with media; and after 6 days of incubation it was caused by filtrates of F. sulphureum (Fs1564) and G. pulicaris (Gp2). In the case of sprout length, the weakest effect was exerted by filtrates of G. zeae (Gz2) and H. haematococca (Hh776) in both incubation periods, and the impact was comparable to the control with media. The other hand, the greatest influence on inhibition of seed germination and growth of sprouts was caused by filtrates of F. poae (Fp2) and G. fujikuroi (Gf1) in both incubation periods (Table 4).
The weakest effect on electronic conductivity of exudates, the growth of seedlings and leaves of garden cress was exerted by the control with redistilled water. On the other hand, the largest destabilization of cell membranes of intact plants was caused by fungal culture filtrates, and in the case of leaves by fungal filtrates and the control with media – the value was statistically significant (Fig. 4). The growth of cress was most limited by the control with medium and by fungal filtrates – the values of these variants were not statistically significant (Fig. 5).
Culture filtrates obtained from individual strains differently affected the destabilization of cell membranes of seedlings and leaves and their growth – the values were statistically significant. The highest values of exudate electroconductivity for seedlings and leaves were recorded for samples with the filtrate of G. fujikuroi (Gf1). The filtrate from this fungus also limited the growth of seedlings and leaves the most. On the other hand, the smallest side effects on the cell membranes of seedlings and the length of plants and leaves were exerted by the control with redistilled water, and in the case of the cell membranes of leaves also the control with redistilled water and fungal filtrates of F. culmorum (Fc1) and G. pulicaris (Gp2) (Table 5).
Discussion
Studies of enzyme production by a phytopathogenic fungus is complicated, particularly due to the presence of plant enzymes and microbial enzyme inhibitors that occur in the plants. The most practical way to study the production of enzymes by a fungus is therefore to study the production of its enzymes on artificial growth media that contain no plant or enzyme inhibitors produced by the plant (Moreira et al. 2005). However, the production of enzymes by microorganisms in vitro compared to natural conditions can vary, e.g., due to the type of medium or culture, which are not dependent on the genotype of a microorganism (Urbanek 1987).
Fungi are important pathogens of plants and cause more significant yield losses than bacteria or viruses. However, bacteria and viruses are more important than fungi as pathogens of animals (Sexton and Howlett 2006). Extracellular proteins secreted by fungi are able to macerate tissues and degrade cell wall components (Baer and Gudmestad 1995). They must thus contain the enzymes corresponding to the types of glycosidic linkages present in the cell wall polysaccharides. Extracellular enzymes are important to fungi not only for digestion but also in many instances for the pathogenic process. The enzymes may function in overcoming the natural resistance of the host as well as in providing soluble products that can be absorbed and used as food (North 1982; Dobinson et al. 1996; Pekkarinen et al. 2000). Thorough research reported in the literature has been focused on trying to determine the role and importance of extracellular cell wall-degrading enzymes related to the virulence of plant pathogenic fungi. In several cases conclusive evidence has been obtained for the role of enzymes in the infection process (Nightingale et al. 1999; Pekkarinen et al. 2000; Oeser et al. 2002; Shimokawa et al. 2002; Feng et al. 2005; Jenczmionka and Schäfer 2005). Thus, to gain entrance to plant cells, fungi generally secrete a mixture of hydrolytic enzymes including cutinases, cellulases, pectinases and proteases (Knogge 1996). However, pectinases have proved to be decisive in the infection process of various phytopathogenic fungi, as pectin degradation results in weakening of cell walls, leading to penetration of fungi (Valette-Collet et al. 2003). These enzymes cause modification of cell wall structure, increasing accessibility of cell wall components for degradation by other enzymes, cell lysis and plant tissue maceration (Panda et al. 2004). Pectic enzymes are the first polysaccharidases to be induced when fungi are cultured on isolated plant cell walls and the first produced in infected tissue (Martínez et al. 1991; Niture et al. 2006). Most fungi used in the study synthesized protease (95.2 %), then cellulase and amylase, and pectinase the least. However, the pectolytic enzymes produced by the isolates showed high enzyme activity. Among the examined fungi are isolates which able to actively infect the interior of plants. This confirms other reports that Fusarium spp. are able to produce enzymes that act upon the pectic and cellulose components of cell walls of host plants (Pritsch et al. 2000; Kang and Buchenauer 2000a, b; Roncero et al. 2003; Phalip et al. 2005). However, taking into account only the results of in vitro enzymatic studies, the role of a microorganism in the pathogenesis of a plant cannot be defined (Urbanek 1987). In addition, after penetration, the fungus often secretes toxins or plant hormone-like compounds that manipulate the plant’s physiology to the benefit of the pathogen (Knogge 1996). This is often achieved through the production of phytotoxins with varying degrees of specificity towards different plants (Walton 1994).
According to Haikal (2008), fungal filtrates from F. culmorum irrespective of filtrate concentrations, filtrate age and the presoaking period significantly reduced percentage seed germination and seedling development of soybean (Glycine max). Other authors have reported that culture filtrate from other species of Fusarium can also reduce percentage seed germination and seedling growth of various plants. For example, culture filtrate from G. intricans had a negative effect on seed germination and seedling growth of cumin, from H. haematococca and F. oxysporum on seeds of soybean, from G. fujikuroi, F. incarnatum and F. oxysporum on seeds and roots of sorghum, and from F. oxysporum on tomato seedlings (Dwivedi 1988; Khurshid et al. 2014; Suthar et al. 2014). It is confirmed by the results of this study that culture filtrates from the above-listed species also negatively affected seeds and seedlings of garden cress. In addition, fungal filtrates from species such as F. poae, F. reticulatum, F. sulphureum, G. avenacea, G. pulicaris, G. zeae and H. haematococca caused reduced percentage seed germination, sprout and seedling growth of garden cress. However, F. poae (Fp2) and G. fujikuroi (Gf1) most strongly reduced seed germination and sprout growth, and only G. fujikuroi (Gf1) most strongly affected growth and destabilization of cell membranes in seedlings.
In this study the control of medium also exerted an effect on seed germination and growth of sprouts, seedlings, and electrical conductivity of exudates from garden cress. Most likely, the medium caused stress conditions for seeds and seedlings due to the concentration of nutrients, e.g., polysaccharides. Therefore, it could enhance the effect of fungal filtrates on garden cress. According to Csonka (1989), the increase in extracellular osmotic pressure is the cause of water flow in accordance with the concentration gradient. This results in dehydration of the cytoplasmic components, plasmolysis, and in extreme cases can lead to cell death.
Conclusions
The fungi used in the present study showed significant differences in the ability to secrete enzymes with different activities, and their culture filtrates also had different effects on seeds and seedlings of garden cress. However, all fungal filtrates caused reduced percentage seed germination and growth of sprouts and seedlings, and caused increased destabilization of cell membranes of seedlings, as measured by the increase in electrical conductivity. Fungal enzyme abilities, in particular of secreting pectinases and cellulases, do not determine the impact of their culture filtrates on seed and seedling growth. Fusarium poae (Fp2) and Gibberella fujikuroi (Gf1) most strongly reduced seed germination and sprout growth, and G. fujikuroi (Gf1) most strongly affected growth and destabilization of cell membranes in seedlings. However, these fungi do not secrete pectinases, and the other enzymes are synthesized in small quantities compared to the other tested fungi. Probably other secondary metabolites synthesized by these fungi have a negative influence on seeds and seedlings of garden cress. The plant used in this study (garden cress) is very sensitive to external factors. Therefore, in the near future, different model plants e.g., cereals, which are less sensitive to external factors, will be used for in-depth characterization of the toxicological influence of culture filtrates from Fusarium spp. and Gibberella spp. on plants
References
Agarwal, N., & Sharma, S. (2013). Garden cress (Lepidium sativum L.) – a non conventional traditional plant item for food product. Indian Journal of Traditional Knowledge, 12, 699–706.
Aoki, T., O’Donnell, K., & Scandiani, M. (2005). Sudden death syndrome of soybean in South America is caused by four species of Fusarium: Fusarium brasiliense sp. nov., F. cuneirostrum sp. nov., F. tucumaniae and F. virguliforme. Mycoscience, 46, 162–183.
Baer, D., & Gudmestad, N. C. (1995). In vitro cellulolytic activity of the plant pathogen Clavibacter michiganensis subsp. sepedonicus. Canadian Journal of Plant Pathology, 41, 877–888.
Bai, G. H., Desjardins, A. E., & Plattner, R. D. (2002). Deoxynivalenol-nonproducing Fusarium graminearum causes initial infection, but does not cause disease spread in wheat spikes. Mycopathologia, 153, 91–98.
Bliss, C. T. (1934). The method of probits. Science, 79, 38–39.
Boot, C. (1971). The genus Fusarium. Kew: Commonwealth Mycological Institute.
Chang, D. C., Grant, G. B., O’Donnell, K., Wannemuehler, K. A., Noble-Wang, J., Rao, C. Y., Jacobson, L. M., Crowell, C. S., Sneed, R. S., Lewis, F. M. T., Schaffzin, J. K., Kainer, M. A., Genese, C. A., Alfonso, E. C., Jones, D. B., Srinivasan, A., Fridkin, S. K., & Park, B. J. (2006). A multistate outbreak of Fusarium keratitis associated with use of a contact lens solution. Journal of the American Medical Association, 296, 953–963.
Coleman, J. J., Rounsley, S. D., Rodriguez-Carres, M., Kuo, A., Wasmann, C. C., Grimwood, J., Schmutz, J., Taga, M., White, G. J., Zhou, S., Schwartz, D. C., Freitag, M., Ma, L.-J., Danchin, E. G. J., Henrissat, B., Coutinho, P. M., Nelson, D. R., Straney, D., Napoli, C. A., Barker, B. M., Gribskov, M., Rep, M., Kroken, S., Molnár, I., Rensing, C., Kennell, J. C., Zamora, J., Farman, M. L., Selker, E. U., Salamov, A., Shapiro, H., Pangilinan, J., Lindquist, E., Lamers, C., Grigoriev, I. V., Geiser, D. M., Covert, S. F., Temporini, E., & VanEtten, H. D. (2009). The genome of Nectria haematococca: contribution of supernumerary chromosomes to gene expansion. PLoS Genetics, 5(8), e1000618. doi:10.1371/journal.pgen.1000618.
Csonka, L. N. (1989). Physiological and genetic responses of bacteria to osmotic stress. Microbiology Reviews, 53, 121–147.
Datta, P. K., Diwakar, B. T., Viswanatha, S., Murthy, K. N., & Naidu, K. A. (2011). Safety evaluation studies on garden cress (Lepidium sativum L.) seeds in Wistar rats. International Journal of Applied Research in Natural Products, 4, 37–42.
Daud, M. E. (1986). Tissue culture and the selection of resistance to pathogens. Annual Review of Phytopathology, 24, 159–186.
Desjardins, A. E., Proctor, R. H., Bai, G. H., McCormick, S. P., Shaner, G., Buchley, G., & Hohn, T. M. (1996). Reduced virulence of trichothecene-nonproducing mutants of Gibberella zeae in wheat field tests. Molecular Plant-Microbe Interactions, 9, 775–781.
Desjardins, A. E., Munkvold, G. P., Plattner, R. D., & Proctor, R. H. (2002). FUM1 – a gene required for fumonisin biosynthesis but not for maize ear rot and ear infection by Gibberella moniliformis in field tests. Molecular Plant-Microbe Interactions, 15, 1157–1164.
Desmond, O. J., Manners, J. M., Stephens, A. E., Maclean, D. J., Schenk, P. M., Gardiner, D. M., Munn, A. L., & Kazan, K. (2008). The Fusarium mycotoxin deoxynivalenol elicits hydrogen peroxide production, programmed cell death and defence responses in wheat. Molecular Plant-Microbe Interactions, 9, 435–445.
Diwakar, B. T., Dutta, P. K., Lokesh, B. R., & Naidu, K. A. (2010). Physicochemical properties of garden cress (Lepidium sativum l.) seed oil. Journal of the American Oil Chemists’ Society, 87, 539–548.
Dobinson, K. F., Lecomte, N., & Lazarovits, G. (1996). Production of an extracelular trypsin-like protease by the fungal plant pathogen Verticillium dahliae. Canadian Journal of Microbiology, 43, 227–233.
Doke, S., & Guha, M. (2014). Garden cress (Lepidium sativum L.) seed - an important medicinal source: a Review. Journal of Natural Product and Plant Resources, 4, 69–80.
Dwivedi, R. (1988). Effect of growth products of staled fungal spp. on germination and field of exotic potato culture. Indian Phytopathology, 41, 500–502.
Eddouks, M., Maghrani, M., Zeggwagh, N. A., & Michel, J. B. (2005). Study of the hypoglycemic activity of Lepidium sativum L. aqueous extract in normal and diabetic rats. Journal of Ethnopharmacology, 97, 391–395.
Fairchild, J. F., Ruessler, D. S., Haverland, P. S., & Carlson, A. R. (1997). Comparative sensitivity of Selenastrum capricornutum and Lemna minor to sixteen herbicides. Archives of Environmental Contamination and Toxicology, 32, 353–357.
Fairchild, J. F., Ruessler, D. S., & Carlson, A. R. (2009). Comparative sensitivity of five species of macrophytes and six species of algae to atrazine, metribuzin, alachlor, and metolachlor. Environmental Toxicology and Chemistry, 17, 1830–1834.
Feng, J., Liu, G., Selvaraj, G., Hughes, G. R., & Wei, Y. (2005). A secreted lipase encoded by LIP1 is necessary for efficient use of saturated triglyceride lipids in Fusarium graminearum. Microbiology, 151, 3911–3921.
Gardiner, D. M., McDonald, M. C., Covarelli, L., Solomon, P. S., Rusu, A. G., Marshall, M., Kazan, K., Chakraborty, S., McDonald, B. A., & Manners, J. M. (2012). Comparative pathogenomics reveals horizontally acquired novel virulence genes in fungi infecting cereal hosts. PLoS Pathogy, 8, e1002952. doi:10.1371/journal.ppat.1002952.
Geiser, D. M., Aoki, T., Bacon, C. W., Baker, S. E., Bhattacharyya, M. K., Brandt, M. E., Brown, D. W., Burgess, L. W., Chulze, S., Coleman, J. J., Correll, J. C., Covert, S. F., Crous, P. W., Cuomo, C. A., De Hoog, G. S., Di Pietro, A., Elmer, W. H., Epstein, L., Frandsen, R. J., Freeman, S., Gagkaeva, T., Glenn, A. E., Gordon, T. R., Gregory, N. F., Hammond-Kosack, K. E., Hanson, L. E., Jímenez-Gasco Mdel, M., Kang, S., Kistler, H. C., Kuldau, G. A., Leslie, J. F., Logrieco, A., Lu, G., Lysøe, E., Ma, L. J., McCormick, S. P., Migheli, Q., Moretti, A., Munaut, F., O’Donnell, K., Pfenning, L., Ploetz, R. C., Proctor, R. H., Rehner, S. A., Robert, V. A., Rooney, A. P., Bin Salleh, B., Scandiani, M. M., Scauflaire, J., Short, D. P., Steenkamp, E., Suga, H., Summerell, B. A., Sutton, D. A., Thrane, U., Trail, F., Van Diepeningen, A., Vanetten, H. D., Viljoen, A., Waalwijk, C., Ward, T. J., Wingfield, M. J., Xu, J. R., Yang, X. B., Yli-Mattila, T., & Zhang, N. (2013). One fungus, one name: defining the genus Fusarium in a scientifically robust way that preserves longstanding use. Phytopathology, 103, 400–408.
Gokavi, S. S., Malleshi, N. G., & Guo, M. (2004). Chemical composition of garden cress (Lepidium sativum) seeds and its fractions and use of bran as a functional ingredient. Plant Foods for Human Nutrition, 59, 105–111.
Haikal, N. Z. (2008). Effect of filtrates of pathogenic fungi of soybean on seed germination and seedling parameters. Journal of Applied Sciences Research, 4, 48–52.
Idris, A. E., Abouzeid, M. A., Boari, A., Vurro, M., & Evidente, A. (2003). Identification of phytotoxic metabolites of a new Fusarium sp. inhibiting germination of Striga hermonthica seeds. Phytopathologia Mediterranea, 42, 65–70.
Ilgen, P., Maier, F., & Schäfer, W. (2008). Trichothecenes and lipases are host-induced and secreted virulence factors of Fusarium graminearum. Cereal Research Communications, 36, 421–428.
Jenczmionka, N. J., & Schäfer, W. (2005). The Gpmk1 MAP kinase of Fusarium graminearum regulates the induction of specific secreted enzymes. Current Genetics, 47, 29–36.
Juma, A. (2007). The effects of Lepidium sativum, a review of contemporary literature and medicimal properties. Oriental Pharmacy and Experimental Medicine, 7, 331–335.
Kang, Z., & Buchenauer, H. (2000a). Ultraestructural and cytochemical studies on cellulose, xylan and pectin degradation in wheat spikes infected by Fusarium culmorum. Journal of Phytopathology, 148, 263–275.
Kang, Z., & Buchenauer, H. (2000b). Cytology and ultrastructure of the infection of wheat spikes by Fusarium culmorum. Mycological Research, 104, 1083–1093.
Khurshid, S., Shoaib, A., & Javaid, A. (2014). In vitro toxicity evaluation of cultire filtrates of Fusarium oxysporum f.sp. lycopersici on growth and physiology of tomato under chromium (VI) stress. The Journal of Animal & Plant Sciences, 24, 1241–1245.
Knogge, W. (1996). Fungal infection of plants. The Plant Cell, 8, 1711–1722.
Ma, L.-J., Geiser, D. M., Proctor, R. H., Rooney, A. P., O’Donnell, K., Trail, F., Gardiner, D. M., Manners, J. M., & Kazan, K. (2013). Fusarium pathogenomics. Annual Review of Microbiology, 67, 399–416.
Madhosing, C. (1995). Relative wilt-inducing capacity of the culture filtrates of isolates of Fusarium oxysporum f.sp. radicis-lycopersici, the tomato crown and root-rot pathogen. Journal of Phytopathology, 4, 193–198.
Maier, U. H., Gundlach, H., & Zenk, M. H. (1998). Seven imidazole alkaloids from Lepidium sativum. Phytochemistry, 49, 1791–1795.
Martínez, M. J., Alconada, T. M., Guillén, F., Vázquez, C., & Reyes, F. (1991). Pectic activities from Fusarium oxysporum f.sp. melonis. Purification and characterization of an exopolygalacturonase. FEMS Microbiology Letters, 81, 145–150.
Marwood, C. A., Solomon, K. R., & Greenberg, B. M. (2001). Chlorophyll fluorescence as a bioindicator of effects on growth in aquatic macrophytes from mixtures of polycyclic aromatic hydrocarbons. Environmental Toxicology and Chemistry, 20, 890–898.
McLean, M. (1996). The phytotoxicity of Fusarium metabolites: an update since 1989. Mycopathologia, 133, 163–179.
Moreira, F. G., dos Reis, S., Costa, M. A. F., de Souza, C. G. M., & Peralta, R. M. (2005). Production of hydrolytic enzymes by the plant pathogenic fungus Myrothecium verrucaria in submerged cultures. Brazilian Journal of Microbiology, 36, 7–11.
Nelson, P. E., Toussoun, T. A., & Marasas, W. F. O. (1983). Fusarium species. An illustrated manual for identification. University Park: The Pennsylvania State University Press.
Nema, A. G. (1992). Studies on pectinolytic and cellulolytic enzymes produced by Fusarium udum causing wilt of Pigeonpea. Indian Journal of Forestry, 15, 353–355.
Nightingale, M. J., Marchylo, B. A., Clear, R. M., Dexter, J. E., & Preston, K. R. (1999). Fusarium head blight: effect of fungal proteases on wheat storage proteins. Cereal Chemistry, 76, 150–158.
Niture, S. K., Kumar, A. R., & Pant, A. (2006). Role of glucose in production and repression of polygalacturonase and pectate lyase from phytopathogenic fungus Fusarium moniliforme NCIM 1276. World Journal of Microbiology and Biotechnology, 22, 893–899.
North, M. J. (1982). Comparative biochemistry of the proteinases of eucaryotic microorganisms. Microbiology Reviews, 46, 308–340.
O’Donnell, K., Kistler, H. C., Cigelnik, E., & Ploetz, R. C. (1998). Multiple evolutionary origins of the fungus causing Panama disease of banana: concordant evidence from nuclear and mitochondrial gene genealogies. Proceedings of the National Academy of Sciences of the United States of America, 95, 2044–2049.
O’Donnell, K., Kistler, H. C., Tacke, B. K., & Casper, H. H. (2000). Gene genealogies reveal global phylogeographic structure and reproductive isolation among lineages of Fusarium graminearum, the fungus causing wheat scab. Proceedings of the National Academy of Sciences of the United States of America, 95, 7905–7910.
O’Donnell, K., Rooney, A. P., Proctor, R. H., Brown, D. W., McCormick, S. P., Ward, T. J., Frandsen, R. J. N., Lysøe, E., Rehner, S. A., Aoki, T., Robert, V. A. R. G., Crous, P. W., Groenewald, J. Z., Kang, S., & Geiser, D. M. (2013). Phylogenetic analyses of RPB1 and RPB2 support a middle Cretaceous origin for a clade comprising all agriculturally and medically important fusaria. Fungal Genetics and Biology, 52, 20–31.
Oeser, B., Heidrich, P. M., Müller, U., Tudzynski, P., & Tenberge, K. B. (2002). Polygalacturonase is a pathogenicity factor in the Claviceps purpurea/rye interaction. Fungal Genetics and Biology, 36, 176–186.
Panda, T., Nair, S. R., & Kumar, P. (2004). Regulation of synthesis of the pectolytic enzymes of Aspergillus niger. Enzyme Microbiology Technics, 34, 466–473.
Pekkarinen, A. I., Mannonen, L., Jones, B. L., & Niku-Paavola, M. L. (2000). Production of proteases by Fusarium species grown on barley grains and in media containing cereal proteins. Journal of Cereal Science, 31, 253–261.
Phalip, V., Delande, F., Carapito, C., Goubet, F., Hatsch, D., Leize-Wagner, E., Dupree, P., Van Dorsselaer, A., & Jetsch, J.-M. (2005). Diversity of the exoproteome of Fusarium graminearum grown on plant cell wall. Current Genetics, 48, 366–379.
Pritsch, C., Muehlbauer, G. J., Bushnell, W. R., Somers, D. A., & Vance, C. P. (2000). Fungal development and induction of defense response genes during early infection of wheat spikes by Fusarium graminearum. Molecular Plant-Microbe Interactions Journal, 13, 159–169.
Raval, N. D., & Pandya, T. N. (2011). Pharmacognostic study of Lepidium sativum Linn (Chandrashura). Ayu, 32, 116–119.
Rehman, N.-U., Khan, A.-U., Alkharfy, K. M., & Gilani, A.-H. (2012). Pharmacological basis for the medicinal use of Lepidium sativum in airways disorders. Evidence-based Complementary and Alternative Medicine, 8, doi: 10.1155/2012/596524.
Roncero, M. I. G., Hera, C., Ruiz-Rubio, M., García-Maceira, F. I., Madrid, M. P., Caracuel, Z., Calero, F., Delgado-Jarana, J., Roldán-Rodriguez, R., & Martínez-Rocha, A. L. (2003). Fusarium as a model for studying virulence in soilborne plant pathogens. Physiological and Molecular Plant Pathology, 62, 87–98.
Sexton, A. C., & Howlett, B. J. (2006). Parallels in fungal pathogenesis on plant and animal hosts. Eukaryotic Cell, 5, 1941–1949.
Sharma, S., Singh, A. K., Singh, R. P., Singh, M. K., Singh, P., & Mohapatra, C. (2015). Effects of plant growth regulator on in vitro callogenesis of Garden cress (Lepidum sativum L.). The Bioscan, 10, 167–171.
Shimokawa, T., Kakegawa, K., & Ishii, T. (2002). Feruloyl esterases from suspension-cultured rice cells. Bulletin FFPRI, 1, 225–230.
Su, L. J., & Arab, L. (2006). Salad and raw vegetable consumption and nutritional status in the adult US population: results from the third national health and nutrition examination survey. Journal of the American Dietetic Association, 106, 1394–1404.
Suthar, R., Bhatt, D. P., & Bhatt, P. N. (2014). Effect of culture filtrate of Fusarium equiseti on seed germination and seedling growth of cumin (Cuminumcyminum). Indian Phytopathology, 67, 193–194.
Sutton, D. A., & Brandt, M. E. (2011). Fusarium and other opportunistic hyaline fungi. In J. Versalovic, K. C. Carroll, G. Funke, J. H. Jorgensen, M. L. Landry, & D. W. Warnock (Eds.), Manual of clinical microbiology (10th ed., pp. 1853–1879). Washington: ASM Press.
Svábová, L., Lebeda, A., Kitner, M., Sedlárová, M., Petrivalsky, M., Dostálová, R., Ondrej, M., Horácek, J., Smykalová, I., & Griga, M. (2011). Comparison of the effects of Fusarium solani in vitro and in vivo on the morphological characteristics and peroxidase activity in pea cultivars with different susceptibility. Journal of Plant Pathology, 93, 19–30.
Tuncay, O., Esiyok, D., Yagmur, B., & Okur, B. (2011). Yield and quality of Garden cress affected by different nitrogen sources and growing period. African Journal of Agriculture Research, 6, 608–617.
Urbanek, H. (1987). The role of the enzyme in the interaction higher plant-pathogen. Wiadomości Botaniczne, 31, 15–28 [in Polish].
Valette-Collet, O., Cimerman, A., Reignault, P., Levis, C., & Boccara, M. (2003). Disruption of Botrytis cinerea pectin methylesterase gene Bcpme1 reduces on several host plans. Molecular Plant-Microbe Interactions Journal, 16, 360–367.
van der Does, C., Duyvesteijn, R. G. E., Goltstein, P. M., van Schie, C. C. N., Manders, E. M. M., Cornelissen, B. J. C., & Repet, M. (2008). Expression of effector gene SIX1 of Fusarium oxysporum requires living plant cells. Fungal Genetic and Biology, 45, 1257–1264.
Wagh, P., Sinha, S., Singh, H. K., & Khare, U. K. (2013). Pathogenic behaviour of Alternaria alternata and phytotoxicity of its culture filtrates on Lepidium sativum: a medicinal herb of immense pharmacological potential. The Bioscan, 8, 643–647.
Walton, J. D. (1994). Deconstructing the cell wall. Plant Physiology, 104, 191–196.
Woloshuk, C. P., & Shim, W.-B. (2013). Aflatoxins, fumonisins, and trichothecenes: a convergence of knowledge. FEMS Microbiology Reviews, 37, 94–109.
Wu, F. (2007). Measuring the economic impacts of Fusarium toxins in animal feeds. Animal Feed Science and Technology, 137, 363–374.
Author information
Authors and Affiliations
Corresponding author
Rights and permissions
About this article
Cite this article
Ogórek, R. Enzymatic activity of potential fungal plant pathogens and the effect of their culture filtrates on seed germination and seedling growth of garden cress (Lepidium sativum L.). Eur J Plant Pathol 145, 469–481 (2016). https://doi.org/10.1007/s10658-016-0860-7
Accepted:
Published:
Issue Date:
DOI: https://doi.org/10.1007/s10658-016-0860-7